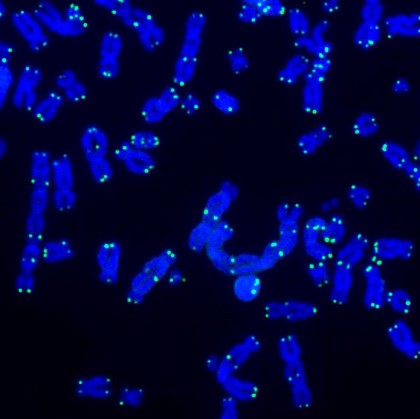

Telomerii, mitocondriile și inflamația, trei elemente distincte ce lucrează împreună pentru a preveni cancerul
Conform oamenilor de știință, Jan Karlseder, profesor la institutul american și autor la studiului, afirmă că, atunci când telomerii se scurtează până în punctul în care nu mai pot oferi cromozomilor proprietăți de apărare împotriva deteriorării, are loc un proces prin care celulele ce au suferit modificări de această natură mor. Acesta este unul natural, ce constă în eliminarea celulelor cu telomeri foarte scurti și genom instabili, fiind totodată cunoscut drept o barieră puternică împotriva formării cancerului. Autorul, alături de colegul său, profesorul Joe Nassour, a descoperit în cadrul unor studii anterioare că aceste celule sunt îndepărtate printr-un proces numit autofagie, în care organismul se curăță de celulele deteriorate.
Subiectul studiului curent a fost reprezentat de identificarea modalității prin care sunt activate programele de moarte celulară dependente de autofagie în timpul crizei celulare generate de scurtarea telomerilor, prin efectuarea unui screening genetic folosind fibroblaste. Astfel, specialiștii au descoperit diferite căi interdependente de detectare imunitară și de semnalizare inflamatorie, similare celor prin care sistemul imunitar luptă împotriva virușilor, cruciale pentru apoptoza celulelor. Mai exact, ei au descoperit faptul că moleculele de ARN pe care telomerii scurti le emană activează senzori imuni pe suprafața exterioară a mitocondriilor, ce poartă denumirea de ZBP1 și MAVS.
Gerald Shadel, director al Centrului Nathan Shock din San Diego, menționează și faptul că telomerii, mitocondriile și inflamația sunt trei semne distinctive ale îmbătrânirii care sunt cel mai adesea studiate în mod izolat. Cu toate acestea, în cadrul lucrării a fost evidențiat faptul că telomerii ce prezintă modificări structurale precum reducerea lungimii trimit un mesaj de tip ARN mitocondriilor, în vederea provocării inflamației. Astfel, conform doctorului, este evidențiată nevoia de a studia în continuare interacțiunile dintre aceste elemente, pentru a înțelege pe deplin procesul de îmbătrânire și pentru a dezvolta noi modalități de creștere a duratei de viață a oamenilor și de îmbunătățire a stării lor de sănătate.
sursa: Science Daily
foto: Telomeri (verde) și ADN (albastru) în timpul reparării ADN-ului. Salk Institute
Data actualizare: 18-03-2023 | creare: 18-03-2023 | Vizite: 738
Bibliografie
Telomeres, mitochondria, and inflammation oh my! Three hallmarks of aging work together to prevent cancer, link: https://www.sciencedaily.com/releases/2023/02/230208125046.htm ©
Copyright ROmedic: Articolul se află sub protecția drepturilor de autor. Reproducerea, chiar și parțială, este interzisă!
Alte articole din aceeași secțiune:
- Din ce motiv imunoterapia împotriva cancerului este ineficientă pentru anumiți pacienți?
- S-a descoperit o nouă abordare a melanomului metastatic
- Australia, prima țară din lume care va elimina cancerul de col uterin
- Prognosticul evoluției cancerului mamar: testele genice, folosite pentru a evalua necesitatea efectuării chimioterapiei adjuvante
Din Ghidul de sănătate v-ar putea interesa și:
Forumul ROmedic - întrebări și răspunsuri medicale:
Pe forum găsiți peste 500.000 de întrebări și răspunsuri despre boli sau alte subiecte medicale. Aveți o întrebare? Primiți răspunsuri gratuite de la medici.- Implant silicon sani
- Pentru cei cu anxietate si atacuri de panica FOARTE IMPORTANT
- GRUP SUPORT PENTRU TOC 2014
- Histerectomie totala cu anexectomie bilaterala
- Grup de suport pentru TOC-CAP 15
- Roaccutane - pro sau contra
- Care este starea dupa operatie de tiroida?
- Helicobacter pylori
- Medicamente antidepresive?
- Capsula de slabit - mit, realitate sau experiente pe oameni